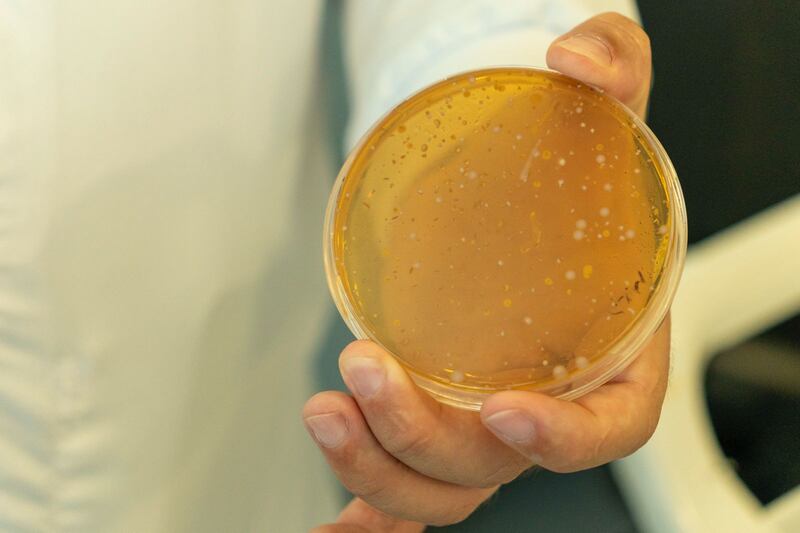
Laboratorio de Alpina

En Entrerríos, Antioquia, funciona la planta más tecnológica de la industria láctea en Colombia. Allí, la biotecnología se aplica a los alimentos lo que se ha convertido en una innovación a escala industrial, con la incorporación de la fibra GOS en un producto fermentado. Este logro consolida a esta planta como el epicentro de la investigación, el desarrollo y la producción de alimentos.
PUBLIMETRO COLOMBIA recorrió los laboratorios y la planta de producción de Alpina, que con 15 años de funcionamiento, diariamente procesa miles de litros de leche de la más alta calidad, proveniente de 250 fincas productoras de la región.

También le puede interesar: Una Capilla Sixtina a la mitad de su tamaño llegó a Medellín con ‘Los Secretos de Miguel Ángel’
Fibra GOS: un hito en la ciencia de los alimentos en Colombia
Uno de los principales logros de la investigación permanente que adelantan entre científicos y microscopios de la compañía, fue el hallazgo de la fibra GOS, (galacto-oligosacáridos), la cual fue incluida dentro de su más reciente bebida fermentada, que protege la salud digestiva y con ingredientes naturales: el Kéfir Plus.
“El proceso de investigación para descubrir y aislar la fibra GOS a partir de la leche comenzó con la identificación de oportunidades para aprovechar el permeado de suero de leche, un subproducto común de la industria láctea. La investigación inicial se realizó en el laboratorio y planta piloto de Alpina, ubicado en Sopó, en colaboración con aliados nacionales e internacionales. A través de la biotecnología enzimática, se desarrolló un proceso de conversión de lactosa en galacto-oligosacáridos (GOS). Cuando se comenzó el proceso de escalado, se inició el trabajo conjunto con la planta de Chinchiná, Caldas, para optimizar y adaptar el proceso a nivel industrial. En esta planta se aprovecharon las capacidades técnicas y equipos especializados para transformar la tecnología de laboratorio en una producción industrial exitosa”, explicó David Orrego, especialista en investigación de Alpina.
La integración definitiva de este nuevo ingrediente se logró en la planta de Entrerríos, considerada la de mayor tecnología en el sector lácteo colombiano.
“La planta de Entrerríos fue crucial para la integración de la fibra GOS en el producto final. Con su experiencia en la producción de productos lácteos fermentados, adaptó sus capacidades para trabajar con el nuevo ingrediente y asegurar su incorporación exitosa en un producto comercializable a gran escala”, señaló Orrego.
De acuerdo con el especialista, el proyecto representó una inversión científica sostenida durante varios años y contó con el aval de las autoridades nacionales en investigación. Además, la compañía invierte cerca de 70.000 millones de pesos al año en temas de investigación, desarrollo e innovación.

“Gran parte de nuestra inversión se ejecutó a lo largo de 4-5 años, a través de proyectos de investigación evaluados y avalados por el Ministerio de Ciencia, Tecnología e Innovación de Colombia. Esta inversión no solo se enfocó en el desarrollo del ingrediente, sino también en la realización de pruebas a nivel de laboratorio para corroborar la calidad y funcionalidad de la fibra GOS”, agregó Orrego.
En tierras antioqueñas está ubicada esta planta que es la primera en la compañía de productos lácteos con todas sus líneas certificadas en FSSC 22000 v6 y la versión más reciente del Food Safety System Certification 22000, un esquema de certificación en seguridad alimentaria reconocido por la GFSI (Iniciativa Mundial para la Seguridad Alimentaria).

Así nació Kéfir Plus, el único de su categoría en Colombia que integra fibra GOS, cuya preparación inicia con leche semidescremada termizada, que pasa por mezcla, homogeneización y pasteurización para garantizar que sea seguro para la salud. Posteriormente se inocula, que se mezclan las bacterias y levaduras, dando paso a la fermentación o acidificación que desarrolla la textura y el sabor característicos. Finalmente, el producto se enfría, se almacena bajo condiciones controladas y, cuando aplica, se adicionan sabores antes de su empaque.

